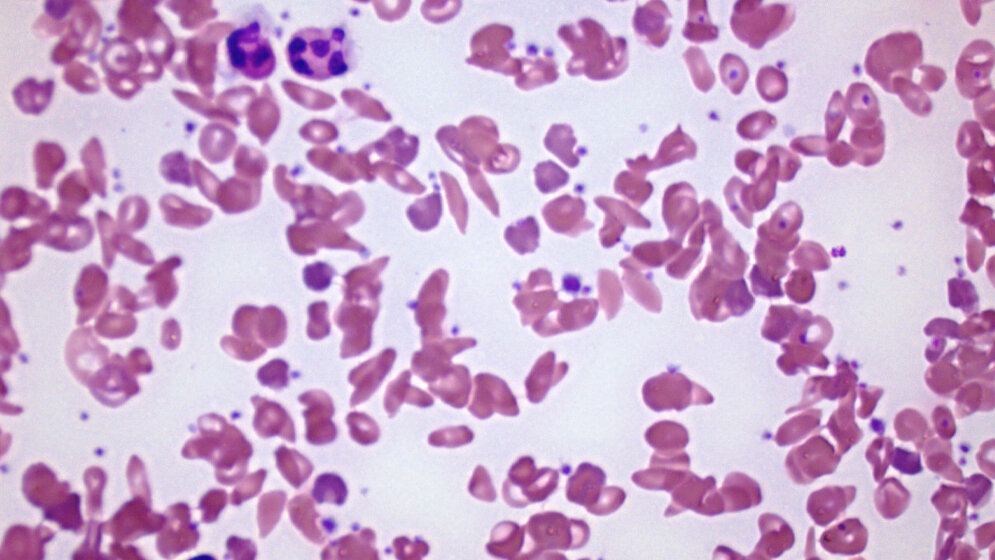
Blutausstrich bei Sichelzellanämie

Im Auftrag des Gemeinsamen Bundesausschusses (G-BA) untersucht das Institut für Qualität und Wirtschaftlichkeit im Gesundheitswesen (IQWiG) derzeit, ob ein Test von Neugeborenen in Deutschland auf die Sichelzellkrankheit sinnvoll wäre. Nach vorläufiger Auswertung der Studienlage sieht das Institut einen Anhaltspunkt für einen Nutzen. Denn im Vergleich zu keinem Screening kann ein solches SCD-Neugeborenenscreening Todesfälle unter den betroffenen Kindern vermeiden. Dieser Anhaltspunkt für einen Nutzen stützt sich auf eine retrospektive, historisch vergleichende Screeningstudie mit einem zwar hohen Verzerrungspotenzial, aber sehr deutlichem Interventionseffekt. Stellungnahmen zum Vorbericht nimmt das IQWiG bis zum 20.05. entgegen.
Blutarmut und verstopfte Gewebe
Die Sichelzellkrankheit (englisch sickle cell disease, kurz SCD) ist eine erbliche Erkrankung des Blutes, die die roten Blutkörperchen betrifft. Der rote Blutfarbstoff (Hämoglobin) ist krankhaft verändert und macht aus den runden, glatten, weichen und gut im Blutstrom beweglichen roten Blutkörperchen spitze, harte, lange Zellen, die wie Sicheln aussehen. Diese „Sichelzellen“ zerfallen schneller als gesunde rote Blutkörperchen, was zur Blutarmut (Anämie) führt. Die sperrigen Sichelzellen bleiben zudem in den Gefäßen vieler Organe hängen. Besonders häufig verstopfen sie die Gefäße der Milz, die dann ihre Abwehrfunktion gegen Erreger nicht mehr gut ausüben kann.
Kinder anfällig für Infektionen
Vor allem Kinder in den ersten Lebensjahren sind sehr anfällig für Infektionen, die oft lebensgefährlich sein können. Deshalb empfehlen medizinische Leitlinien bei betroffenen Kindern ab dem dritten Lebensmonat eine Pneumokokken-Impfung und eine Penizillin-Prophylaxe, die in der Screeningstudie auch untersucht wurde. Allerdings ist diese Behandlung in Deutschland momentan nicht zugelassen und nur im sogenannten Off-Label-Use möglich.
Nur wenige Menschen in Deutschland betroffen
SCD kommt regional sehr unterschiedlich häufig vor und korreliert mit der Ausbreitung von Malaria, weil Betroffene weniger anfällig für deren schwere Verlaufsformen sind. Verlässliche Angaben zur Zahl der in Deutschland mit SCD geborenen Kinder gibt es nicht. Schätzungen gehen davon aus, dass derzeit etwa 3.000 Menschen in Deutschland mit dieser Krankheit leben. Es ist davon auszugehen, dass die SCD in Deutschland nur bei Nachfahren aus der afrikanischen Subsahara, dem östlichen Mittelmeerraum, dem Nahen Osten und Indien auftritt.
Infektionen frühzeitig vermeiden
Ziel eines Neugeborenenscreenings auf SCD ist die frühe Identifikation und Behandlung der betroffenen Kinder. Durch die Vorverlegung der Diagnosestellung in Verbindung mit einer Angehörigenschulung und infektionsprophylaktischen Maßnahmen ab dem dritten Lebensmonat soll die Lebenserwartung der Kinder erhöht werden.
Dabei lässt sich eine SCD über eine Blutprobe diagnostizieren: Auf Filterpapierkarten aufgetropftes, getrocknetes Blut kann dafür verwendet werden. Derzeit gehört die SCD nicht zu den Zielerkrankungen des in Deutschland nach der Kinder-Richtlinie des G-BA durchgeführten Neugeborenenscreenings, für das in der 36. bis 72. Lebensstunde Fersenblut auf Filterpapierkarten getropft wird. In den USA, England, Frankreich, Spanien, den Niederlanden und Belgien ist ein Neugeborenenscreening auf die Sichelzellkrankheit hingegen etabliert.
Hohes Verzerrungspotenzial, aber sehr deutlicher Interventionseffekt
Zur Beantwortung der Frage, ob der Test von Neugeborenen in Deutschland auf die Sichelzellkrankheit sinnvoll wäre, griff das IQWiG zurück auf eine retrospektive, historisch vergleichende Screeningstudie aus Jamaika. Auf der Karibikinsel wurden zwischen 1995 und 2007 insgesamt 150.803 Neugeborene auf SCD gescreent und bei diagnostizierter SCD frühzeitig behandelt. Das heißt, die Kinder erhielten ab dem vierten Lebensmonat eine Penizillin-Prophylaxe und wurden regelmäßig untersucht. Darüber hinaus klärten die Ärztinnen und Ärzte die Eltern umfassend über die Krankheit auf und zeigten ihnen, wie sie bei ihrem Kind Veränderungen der Milz ertasten können. Im Rahmen des Screening wurden 435 Neugeborene mit einer SCD entdeckt, 395 davon waren anschließend Teil des beschriebenen Interventionsprogramms.
Die Entwicklung dieser 395 Kinder verglichen die jamaikanischen Wissenschaftler mit der Entwicklung von 105 Kindern, bei denen die Ärztinnen und Ärzte zwischen 1973 und 1981 ebenfalls auf Jamaika und ebenfalls per Screening unmittelbar nach der Geburt eine SCD diagnostiziert hatten. Allerdings wurden diese Kinder (mangels damaliger Behandlungsmöglichkeiten) in den ersten Lebensjahren nicht behandelt.
Sterblichkeit sinkt um den Faktor 10
Der Effekt durch die frühe Diagnose einer Sichelzellkrankheit in Verbindung mit frühen Interventionsmaßnahmen ist sehr deutlich, denn die Sterblichkeit sinkt um den Faktor 10: Bis zum ersten Lebensjahr verstarben in der Gruppe der frühzeitig behandelten Kinder 0,01 %, in der Gruppe der unbehandelten Kinder waren es 0,1 %. Für die Auswertungen bis zum fünften Lebensjahr zeigen sich konsistente Effekte.
Aufgrund dieser Studienergebnisse sieht das IQWiG einen Anhaltspunkt für einen Nutzen zugunsten eines Neugeborenenscreenings auf SCD in Kombination mit einem Vorverlegen der Diagnosestellung und weiteren Interventionsmaßnahmen.
Zum Ablauf der Berichtserstellung
Den vorläufigen Berichtsplan für dieses vom Gemeinsamen Bundesausschuss (G-BA) in Auftrag gegebene Projekt hatte das IQWiG am 04.09.2018 vorgelegt und um Stellungnahmen gebeten. Die beiden Stellungnahmen dazu machten keine Überarbeitung des Berichtsplans erforderlich. Stellungnahmen zu dem jetzt veröffentlichten Vorbericht werden nach Ablauf der Frist gesichtet. Sofern sie Fragen offenlassen, werden die Stellungnehmenden zu einer mündlichen Erörterung eingeladen. Im Anschluss erstellt das IQWiG den Abschlussbericht.
Quelle: idw/IQWiG
Artikel teilen